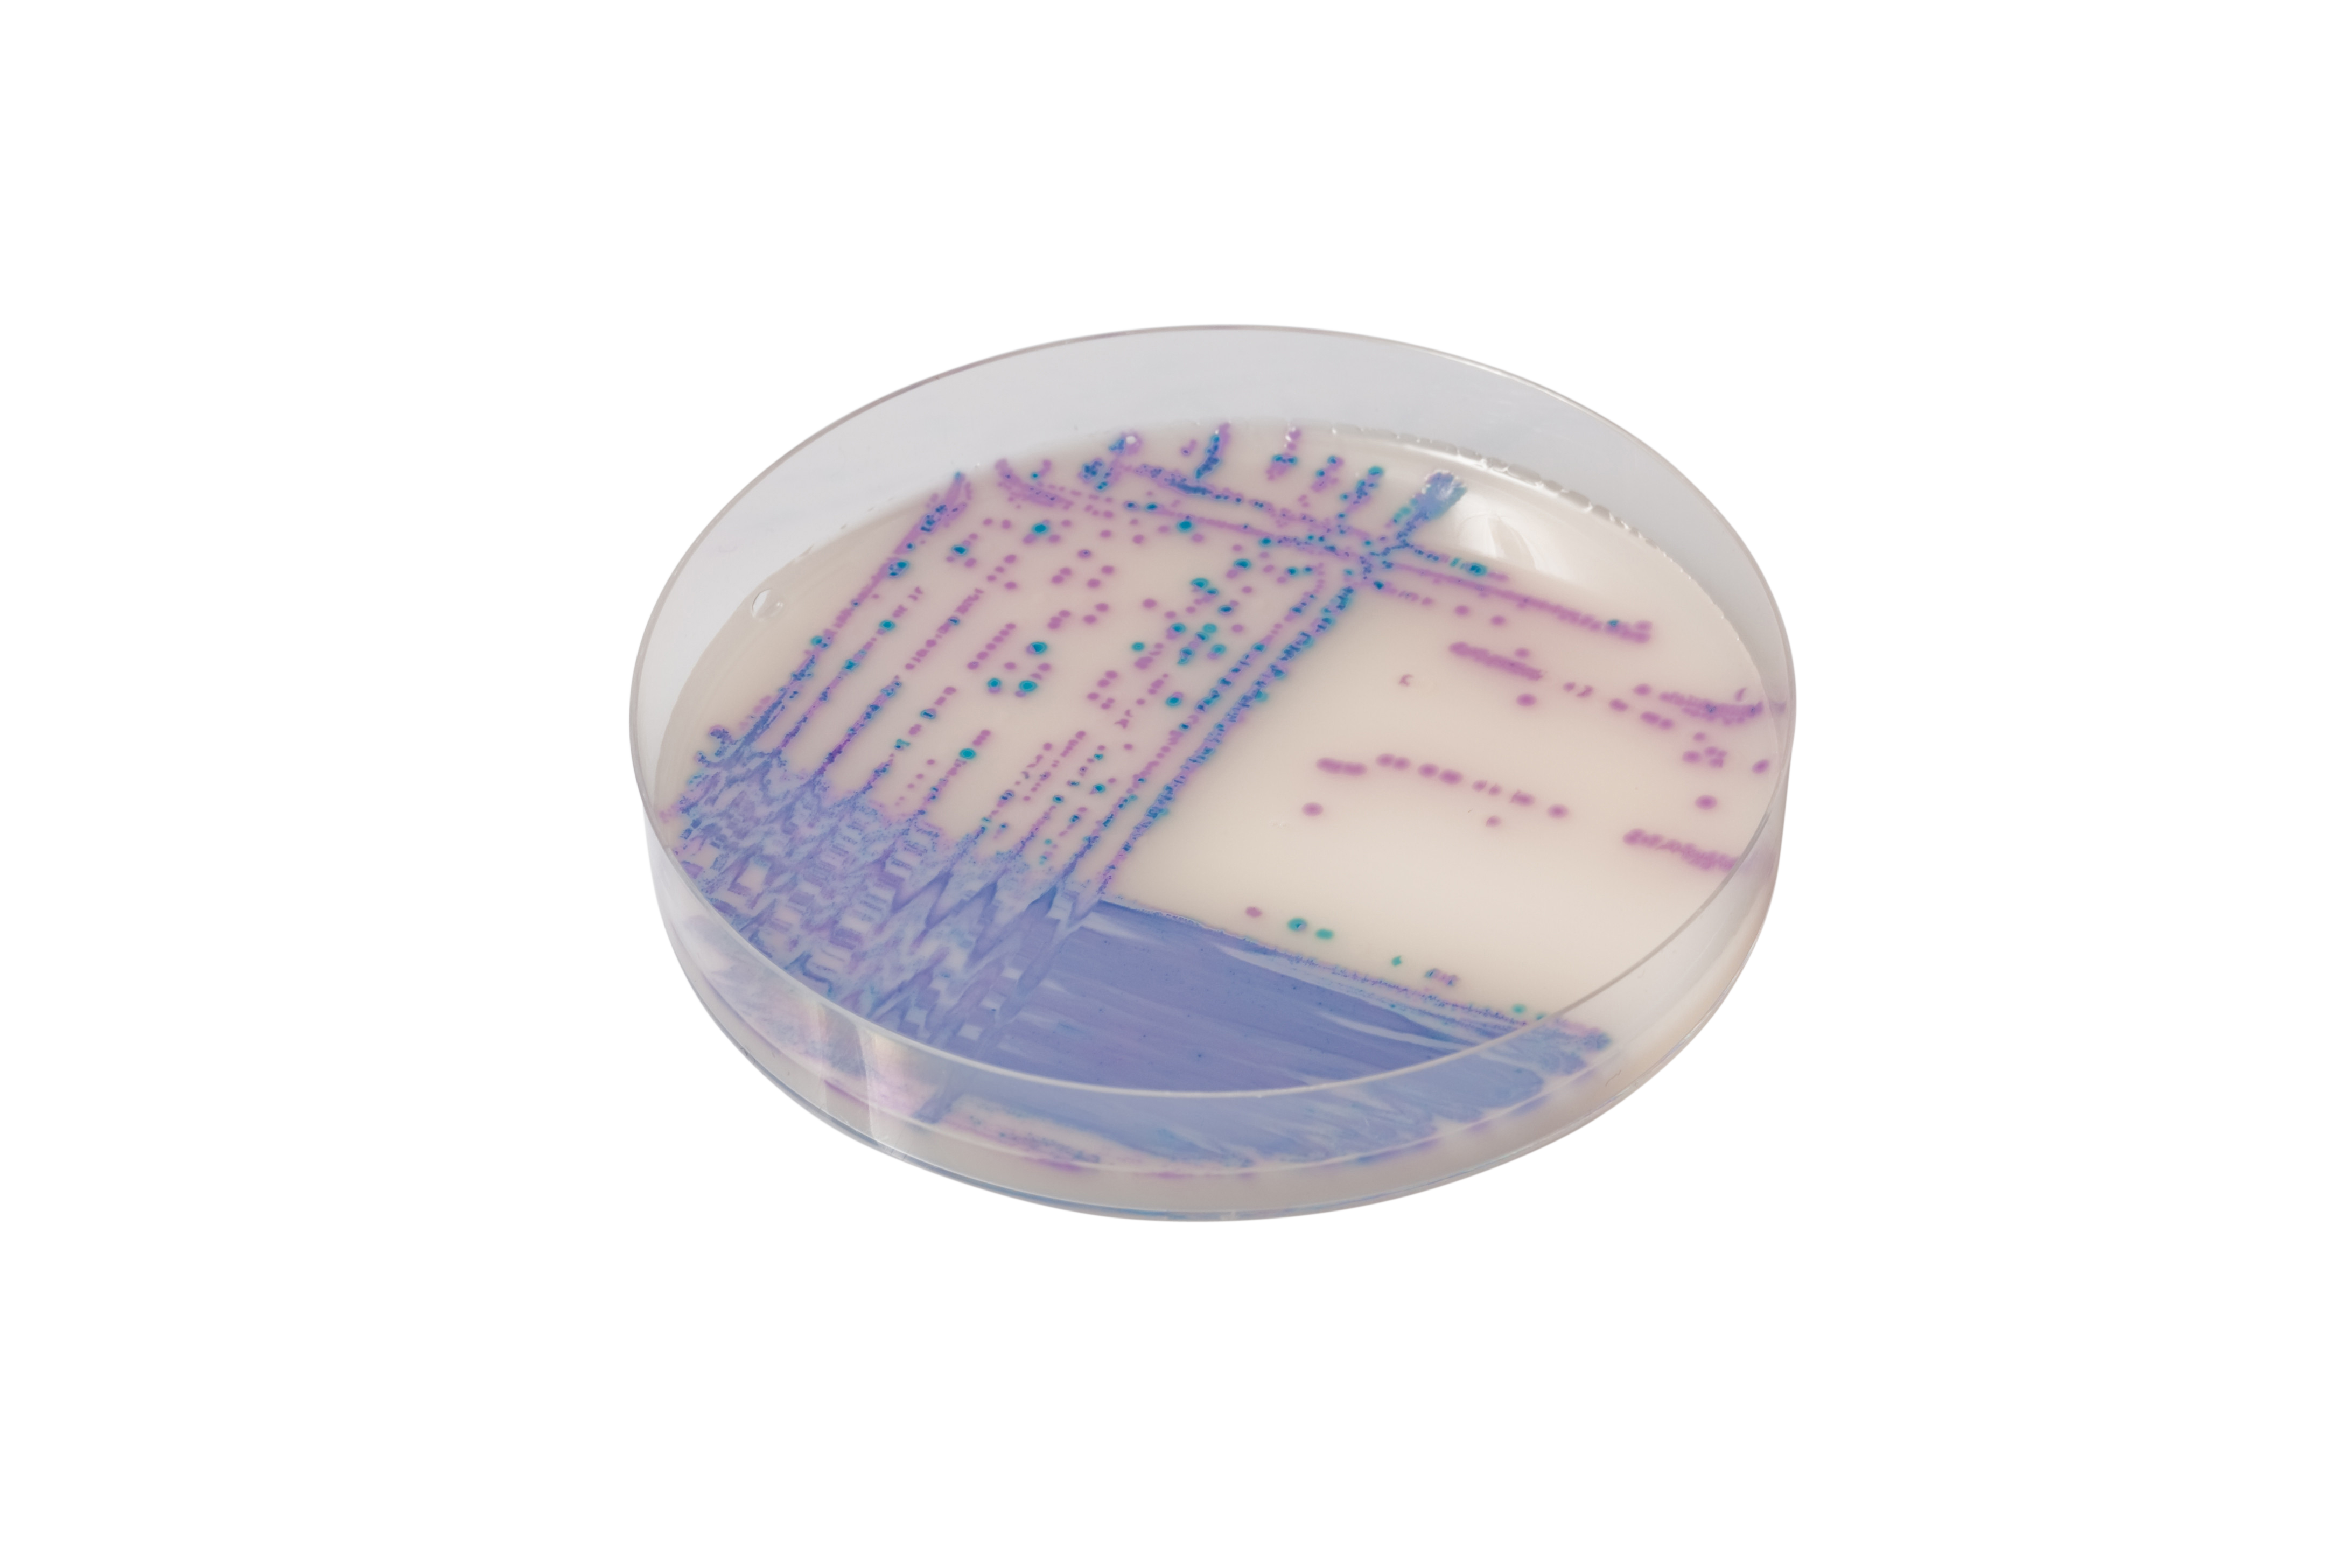

À propos du produit
Milieu chromogène de sélection différentielle pour l’isolement des espèces Salmonella incluant S. typhi et les Salmonella lactose positives.
CHROMAGAR SALMONELLA PLUS

Milieu chromogène de sélection différentielle pour l’isolement des espèces Salmonella incluant S. typhi et les Salmonella lactose positives.